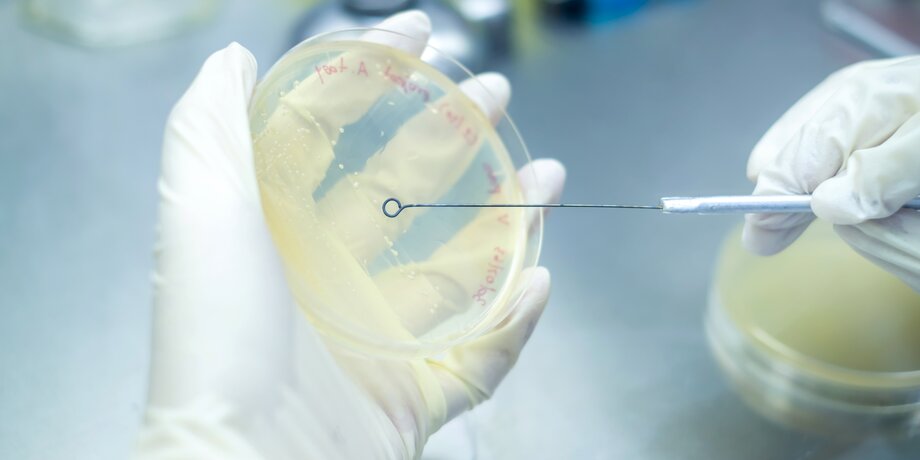

Врач Болибок назвал главную опасность нового подвида коронавируса "Стратус"
В России начал распространяться новый подвид коронавируса "Стратус", предупредили в Роспотребнадзоре. Откуда он появился и способен ли вызывать новую пандемию – в материале Москвы 24.
Еще один вариант
Новый подвид коронавируса "Стратус" (вариант XFG) начал распространяться в России. По данным на 23 июля, выявлено 114 случаев заражения, сообщили в Роспотребнадзоре. Первый из них произошел еще 24 апреля, уточнил заведующий лабораторией геномных исследований ФБУН ЦНИИ эпидемиологии Роспотребнадзора Камиль Хафизов.
По его словам, большая часть случаев пришлась на Москву – 54%. Также заболевшие были в том числе в Московской области, Санкт-Петербурге, Алтайском крае, Вологодской, Иркутской, Калининградской, Магаданской, Московской, Новосибирской, Свердловской, Смоленской, Челябинской областях, а также Ханты-Мансийском и Ямало-Ненецком автономных округах, отметил Хафизов.
В свою очередь, в столичном департаменте здравоохранения заявили, что ситуация со штаммом находится под контролем.
"Одной из ключевых задач департамента здравоохранения остается своевременное реагирование на эпидемиологические изменения, и для этого регулярно проводится полногеномное секвенирование всей линейки респираторных вирусов. По его результатам мы наблюдаем штамм коронавируса "Стратус" (XFG) в линейке вирусов с мая, на текущий момент его доля в структуре всех вирусных заболеваний составляет 22%", – уточнили в ведомстве.
Ранее Всемирная организация здравоохранения (ВОЗ) внесла "Стратус" в перечень "вариантов, вызывающих интерес". Первый случай заболевания был зафиксирован в Канаде 27 января 2025 года. Позднее эксперты фиксировали заражения в других странах Северной Америки, а также Юго-Восточной Азии и Европе.
В России Федеральный оперштаб по борьбе с COVID-19 перестал публиковать еженедельные сводки о заболеваемости в марте 2025 года. Сам же вирус перешел в разряд сезонных заболеваний. В то же время Роспотребнадзор продолжил мониторить эпидемиологическую ситуацию в РФ в оперативном режиме.
Ждать ли новой эпидемии?
Традиционного подъема заболеваемости стоит ждать осенью, предупредил в разговоре с Москвой 24 вирусолог, доктор биологических наук Алексей Аграновский.
Однако врач – аллерголог-иммунолог Владимир Болибок в разговоре с Москвой 24 подчеркнул, что зачастую из-за легкой формы болезни люди не уделяют должного внимания своему здоровью. Это влечет за собой риски осложнений.
"Коварство штамма заключается в том, что он протекает относительно легко и люди не осознают, что они заболевают COVID-19, думая, что это ОРВИ, не делают тесты. А постковидные осложнения – мышечная слабость, когнитивные расстройства, туман в голове, тромбозы, аутоиммунные заболевания, онкология – никуда не делись", – объяснил эксперт.
Особое внимание своему самочувствию должны уделить люди, которые сильнее других подвержены заболеванию.
"Все штаммы коронавируса вызывают более тяжелое течение болезни у людей старше 60–65 лет. В зоне риска и те, кто страдает хроническими заболеваниями сердечно-сосудистой системы, почек, люди со склонностью к тромбозам, варикозному заболеванию вен, а также те, у кого сахарный диабет или перенесенный инсульт или инфаркт", – сказал эксперт.
При этом, по его словам, у детей заболевание коронавирусом протекает в более легкой форме.
Врач также подчеркнул, что риск возникновения эпидемии минимален.
"Сейчас предпосылок к этому нет. Наблюдения говорят о том, что все вирусы, которые ранее циркулировали, вызывая тяжелые течения болезни, исчезли из этого процесса, а "Омикрон" остался. Но он, скорее, вызывает сезонные всплески, быстро передаваясь, но переносясь в достаточно легкой форме, – объяснил Болибок.
Он также напомнил о необходимых мерах профилактики. Во избежание заболевания эксперт рекомендовал сделать прививку от коронавируса, а находящихся в группе риска граждан призвал не отказываться от ношения маски в общественных местах. Это уменьшит риски попадания инфекции в организм, заключил врач.

Зудакова Татьяна
Зудакова Татьяна